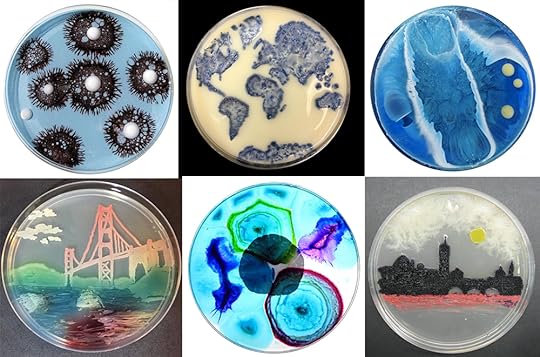
Bacteria materoal ecology design architecture 3d printing pandemic art

Garette Johnson's Blog, page 2
March 20, 2022
Build Expo NYC: Sustainable Cities & Workplace
How can cities be built and designed more sustainably? At Build Expo NYC, conversations emphasized the importance of the construction industry reducing CO2 emissions with innovative and smart sustainable solutions. Additionally, workplace interior design was thought of in sustainable frameworks that raise the work culture, making work itself more efficient and sustainable.

In 2019, NYC had set new sustainable codes to lower emissions by 2024, this included Local Law #97 (LL97). Unfortunately, the pandemic crisis would interrupt those ambitions. This year, it was great to see an even stronger commitment to sustainable initiatives. Conversations around carbon embodiment and high performance building case studies, Intelligent buildings, barriers to implementation, digital disruption, retrofitting design against climate change, and workplaces of the future to name a few.
What is Local Law #97 The Climate Mobilization Act of 2019 included LL97, which set increasingly stringent caps on greenhouse gas emissions from the city’s largest buildings. Starting in 2024, buildings that exceed their annual emissions limit will face financial penalties of $268 per ton of CO2 over the limit based on CO2 tons per square foot. Still, it will be about 3-7 years before we see the impact of Local Law #97.
The Climate Mobilization Act of 2019 included LL97, which set increasingly stringent caps on greenhouse gas emissions from the city’s largest buildings. Starting in 2024, buildings that exceed their annual emissions limit will face financial penalties of $268 per ton of CO2 over the limit based on CO2 tons per square foot. Still, it will be about 3-7 years before we see the impact of Local Law #97.
For the purposes of this article, we’ll explore the barriers to implementation, intelligent buildings and ultimately how the workplace is being redesigned to improve efficiency, deliver value as well as quality of life for clients and employees.
Barriers to Implementation There are many barriers to implementation. While Covid-19 presented its own challenges, financing and outdated investment models were highlighted among them. It was mentioned that the high performance building is one that is already built. Knocking down and rebuilding is perhaps one of the least sustainable things we can do. However, retrofitting existing buildings holds a financial burden while different types of buildings require different types of solutions.
There are many barriers to implementation. While Covid-19 presented its own challenges, financing and outdated investment models were highlighted among them. It was mentioned that the high performance building is one that is already built. Knocking down and rebuilding is perhaps one of the least sustainable things we can do. However, retrofitting existing buildings holds a financial burden while different types of buildings require different types of solutions.
Cost effective and use-financing is feeling pressure by the city codes to upgrade. However, investors also have pressure to sell quickly as opposed to investing for the long term future. The buy low, sell quickly model passes along the risk while much needed improvements become increasingly more expensive and less likely to be addressed. Sooner or later, it will be crucial to flip the building or knock it down. Sustainable improvements will require a long term investor willing to create an asset for future owners.
 Kenneth Lewis, Managing Partner at Skidmore Owings & Merrill (SOM) and former President at the AIA NY Chapter, called for new financial models created in a different way to rate capital spend by separating operational and capital in the form of pace modeling and pace financing.
Kenneth Lewis, Managing Partner at Skidmore Owings & Merrill (SOM) and former President at the AIA NY Chapter, called for new financial models created in a different way to rate capital spend by separating operational and capital in the form of pace modeling and pace financing.
I’ve talked about new business models in relation to the fashion industry in my previous article, Sustainable Fashion from Copenhagen to New York: Going Big on Going Small. It’s a sign of the times that new models of short term and long term investment, development, and measures of Return on Investment (ROI) will be necessary to designing a more sustainable and circular future.
The conversation at Build Expo reminded me of the business models inherent to the Nordic ways of doing business. Known as the “Triple Bottom Line,” Nordic businesses measure and account for investment in the following three areas:
 Focusing on “bottom line” only is a model left over from the industrial age of measurable inputs and outputs. While it’s been a successful model for the last century, new conditions require evolved solutions. Naturally, advancements in technology, knowledge working and diminishing resources require new models and design thinking to advance outdated concepts of profit.
Focusing on “bottom line” only is a model left over from the industrial age of measurable inputs and outputs. While it’s been a successful model for the last century, new conditions require evolved solutions. Naturally, advancements in technology, knowledge working and diminishing resources require new models and design thinking to advance outdated concepts of profit.
The City of New York aims for carbon free electric grind by 2040 requiring a shift for renewable sources capable of closed loop circular energy to modulate according to needs based on the grid. Power over ethernet, reconversions, motion sensors and Internet of Things (IoT) can reconvert to low frequency and redistribute energy, climate controls and air flow resources. Smart buildings may be the only way to get to Net Zero and even generate back into the grid.
Workplaces of the FutureThe application of hybrid work is still evolving and the stigma from management around remote work is changing. NYC post Covid-19 has seen only 1-2 percent footprint reduction in workplace real estate. Other experts expect the workplace to have the next major design overhaul initiative much like we saw residential take during the pandemic.
During the Future of Workplace Panel at Build Expo NYC, Nikhita Iyar, Head of Product Marketing, Strategic Business at Moxtra, emphasized the importance of workflow framework and efficiency to first value delivery to clients.
 Similar sentiments were echoed by Kelly Bacon, Principal & Global Practice Lead, People + Place Advisory at ACOM. Bacon focused on the tech and operational side of hybrid work and need for establishing a new set of behaviors around mixed use working. Bacon described the effect of how quickly tech evolves and the pace in which people adopt tech as incongruent. These “Pace Layers” hold a resistance to change that need to be addressed by organizations when adopting new technology or systems of communication and project management.
Similar sentiments were echoed by Kelly Bacon, Principal & Global Practice Lead, People + Place Advisory at ACOM. Bacon focused on the tech and operational side of hybrid work and need for establishing a new set of behaviors around mixed use working. Bacon described the effect of how quickly tech evolves and the pace in which people adopt tech as incongruent. These “Pace Layers” hold a resistance to change that need to be addressed by organizations when adopting new technology or systems of communication and project management.
The panel also agreed that the future of work is too fluid for schedules. The choice between going to the office or working remotely is going to be about the work, not because it’s Tuesday. People will come and go and use the space for what they need to do. For this reason, organizations and workflow systems need to be agile and office spaces need to be modular.
It was said earlier that redesigning the workplace will be the next movement in design. The new workplace will need to be equal parts functionality and beauty to attract employees back to the office.
The feel of the space will have to be better than at home for employees to choose a place workers want to go to, not a place they have to go to. From air quality to lighting, design and especially culture, organizations will have to test solutions. Designing for the future will require flexibility, infrastructure and materials to transform spaces for comfort, culture, efficiency and safety.
Circular City WeekI was inspired to hear these conversations and see a greater engagement around circular and sustainable solutions. From a design and modular perspective, I work with some of the most sustainable brands in the world. With respect to workplace and residential modular solutions, I am excited to invite you to explore Danish design solutions at Circular City Week. In partnerships with Danish CleanTech Hub and The Consulate General of Denmark, the program will feature sustainable and circular furniture brands for the workplace and home. Join me, May 3rd-5th at 200 Lexington New York Design Center for 3 days celebrating sustainable Danish design. RSVP here.


The post Build Expo NYC: Sustainable Cities & Workplace first appeared on Garrott Designs.
February 15, 2022
Sustainable Fashion from Copenhagen to New York: Go Big on Going Small
Copenhagen Fashion Week (CPHFW) has just wrapped while New York Fashion Week starts today. Women’s Wear Daily reports that despite Covid-19 complications, sustainability hails loud and proud from the Nordics. The WWD article announced that the 2023 Sustainable Requirements put forth by CPHFW in 2020 are being adopted by more regional organizations such as the Icelandic Fashion Council, the Norwegian Fashion Hub and Oslo Runway. Yet, for the American fashion Industry, sustainability remains the elephant in the room. Could New York adopt similar requirements?

As a “recovering” American fashion designer myself (my own wardrobe has literally pulled the closet down from the studs, twice!) I acknowledge the different challenges American mega-brands face across the value chain, from over manufacturing to over consumption. It takes a lot to steer big ships and there are many moving parts including changing consumer behavior.
An Unfashionable History of Too Much
Of course, this is not a new problem. In 1991, activist Jeff Ballinger published a report detailing sweatshop conditions in Nike’s Indonesian factories. The report activated blowback against the unethical manufacturing practices in the industry often attributed to large scale production at minimum cost of labor, but that was only the beginning.

In 1999, author and former senior special writer at the Wall Street Journal, Teri Agins, wrote The End of Fashion, a history of diminishing value brought on by fast fashion, overproduction, and over extended licensing, which has brought the fashion industry where it is today.
In 2007, Dana Thomas, contributing writer at British Vogue and former style writer for New York Times Style Magazine, described how luxury became an “off-the-rack, global commodity” in her book, Deluxe How Luxury Lost its Luster. Thomas also attributes over licensing and over production leading to diluted value, market saturation and focus on the bottom line to the detriment of high-end luxury.
And in 2015, Netflix made the mainstream public aware of The True Cost of Fashion detailing how fast fashion has cost us more than we bargained for. To summarize the elephant in the room, overproduction, over-licensing, saturation of the market, diluted market share and sameness have stagnated the industry.
Wicked Problems
As mentioned, it takes a lot to steer big ships, which is why fashion has unique problems to solve when it comes to viable sustainability across manufacturing and distribution. By implication, American brands should wield a high level of influence to set standards and make demands towards change. However, the challenge then becomes dealing with the complexity of changing a long chain system from end-to-end while it’s still in operation. Unlike Nordic companies that operate on a smaller scale in smaller markets. However, the smaller brands of the Nordics often lament the challenge to influence manufacturing practices. With small run collections and production assortment, it is hard to have much clout when it comes to setting regulation standards or making demands of factories in other countries.

Further, business by nature must be profitable in order to be sustainable. Low-cost / high volume / high return models don’t allow for the long-term investment required to adopt sustainable practices on a large scale. This is where regional policy has influence to subsidize innovation in geographical aspects of the industry. Stakeholders must consider the possibility of a new and evolved return on the investment (ROI). For example, If the industry were to adopt the triple bottom line inherent to the Nordic way of doing business and take small steps towards sustainable values, new models of business can begin to flourish.
Start Small
Over the past four years I have engaged with Nordic fashion organizations in collaboration with the Norwegian and Danish Consulate General of New York. From Oslo, to Copenhagen and back to New York, I can honestly recognize that America does indeed have a unique challenge when it comes to the fashion industry. However, If NYFW and CHPFW can begin the same process CPHFW took to analyze first steps towards reducing negative impacts, innovating the business model and accelerating industry change, we could see significant improvements in 3-5 years.
Last August, I had the pleasure of attending CPHFW and joining Creative Denmark for the launch of their white paper, Sustainability by Design. Having the opportunity to see, first hand, how Danish fashion brands plan to take even the smallest steps towards responsible manufacturing was extremely inspiring. The message is clear, we need stronger industry alignment as well as partnership between government and private sector interests. Beginning with a set of standards and guidelines, NYFW can go a long way to initiating large-scale change. Taking responsibility must first occur industry wide and globally in order to truly move towards sustainability.
“… We talk about responsibility rather than sustainability because there’s really nothing sustainable about fashion,” said Barbara Potts, Co-Founder of Saks Potts (WWD).

Sustainability Requirements
We have to begin, and that means mapping small and achievable steps. The development of CPHFW 2023 Sustainability Requirements is a great place to start. Effective as of January 2023, the requirements stipulate that brands must achieve a minimum of 18 standards within six interlinked focus areas covering the value chain: strategic direction, design, smart material choices, working conditions, consumer engagement and shows. What if NYFW were to adopt its own version of standards within the same six focus areas?
The Six Interlinked Focus Areas:
STRATEGIC DIRECTIONThis area requires strategic action on international standards for human rights, environment and climate. From diversity and equality at the management level to not destroying unsold merchandise. This includes circular systems, investing in new technologies, optimizing logistics and knowledge sharing as part of new strategic requirements.
DESIGNThis area focuses on the design process to increase the quality and value of products economically and materially, and educate the consumer of these values.
SMART MATERIAL CHOICESAmong developing innovative solutions, this area requires at least 50% of collections to be certified, organic, upcycled or recycled and have a preferred materials list in place.
WORKING CONDITIONSThis area challenges existing social inequalities and the negative impacts of employment in the fashion industry with a call for human interaction, a sense of community and the appreciation of human life.
CONSUMER ENGAGEMENTThis area encourages brands to rethink current business models and to inform customers of the fast consumption of fashion that is deeply rooted in societal, behavioral, psychological and economic values and urgently influences consumer engagement.
SHOWSRequires zero waste or actions to offset carbon footprint while participating in shows.

While the requirements establish challenging guidelines to achieve, they are flexible enough for brands to work towards without being eliminated from fashion week participation. Keeping the requirements top of mind empowers brands to move forward. If NYFW were to adopt the requirements it could affect the industry more quickly. If big brands took small actions to fundamentally change manufacturing alone, the industry could move forward on a global scale.
Go Big on Going Small
As mentioned in my article last year at this time, President Biden would have been the first U.S. president to appoint a “fashion czar” on private sector and policy partnership for the industry. It is important that the public and private sector work together to establish a set of standards, defining action points and moving forward with protocols to affect change across supply chains, production, and working conditions.

CPHFW has identified a foundational framework that is agile and applicable. If NYFW adopts and scales a new framework, innovative companies can be both profitable and sustainable. By going big on going small NYFW and CPHFW could make significant gains towards a more sustainable fashion industry.
The post Sustainable Fashion from Copenhagen to New York: Go Big on Going Small appeared first on Garrott Designs.
February 12, 2022
Sustainable Fashion from Copenhagen to New York: Go Big on Going Small
Copenhagen Fashion Week (CPHFW) has just wrapped while New York Fashion Week starts today. Women’s Wear Daily reports that despite Covid-19 complications, sustainability hails loud and proud from the Nordics. The WWD article announced that the 2023 Sustainable Requirements put forth by CPHFW in 2020 are being adopted by more regional organizations such as the Icelandic Fashion Council, the Norwegian Fashion Hub and Oslo Runway. Yet, for the American fashion Industry, sustainability remains the elephant in the room. Could New York adopt similar requirements?

As a “recovering” American fashion designer myself (my own wardrobe has literally pulled the closet down from the studs, twice!) I acknowledge the different challenges American mega-brands face across the value chain, from over manufacturing to over consumption. It takes a lot to steer big ships and there are many moving parts including changing consumer behavior.
An Unfashionable History of Too Much
Of course, this is not a new problem. In 1991, activist Jeff Ballinger published a report detailing sweatshop conditions in Nike’s Indonesian factories. The report activated blowback against the unethical manufacturing practices in the industry often attributed to large scale production at minimum cost of labor, but that was only the beginning.

In 1999, author and former senior special writer at the Wall Street Journal, Teri Agins, wrote The End of Fashion, a history of diminishing value brought on by fast fashion, overproduction, and over extended licensing, which has brought the fashion industry where it is today.
In 2007, Dana Thomas, contributing writer at British Vogue and former style writer for New York Times Style Magazine, described how luxury became an “off-the-rack, global commodity” in her book, Deluxe How Luxury Lost its Luster. Thomas also attributes over licensing and over production leading to diluted value, market saturation and focus on the bottom line to the detriment of high-end luxury.
And in 2015, Netflix made the mainstream public aware of The True Cost of Fashion detailing how fast fashion has cost us more than we bargained for. To summarize the elephant in the room, overproduction, over-licensing, saturation of the market, diluted market share and sameness have stagnated the industry.
Wicked Problems
As mentioned, it takes a lot to steer big ships, which is why fashion has unique problems to solve when it comes to viable sustainability across manufacturing and distribution. By implication, American brands should wield a high level of influence to set standards and make demands towards change. However, the challenge then becomes dealing with the complexity of changing a long chain system from end-to-end while it’s still in operation. Unlike Nordic companies that operate on a smaller scale in smaller markets. However, the smaller brands of the Nordics often lament the challenge to influence manufacturing practices. With small run collections and production assortment, it is hard to have much clout when it comes to setting regulation standards or making demands of factories in other countries.

Further, business by nature must be profitable in order to be sustainable. Low-cost / high volume / high return models don’t allow for the long-term investment required to adopt sustainable practices on a large scale. This is where regional policy has influence to subsidize innovation in geographical aspects of the industry. Stakeholders must consider the possibility of a new and evolved return on the investment (ROI). For example, If the industry were to adopt the triple bottom line inherent to the Nordic way of doing business and take small steps towards sustainable values, new models of business can begin to flourish.
Start Small
Over the past four years I have engaged with Nordic fashion organizations in collaboration with the Norwegian and Danish Consulate General of New York. From Oslo, to Copenhagen and back to New York, I can honestly recognize that America does indeed have a unique challenge when it comes to the fashion industry. However, If NYFW and CHPFW can begin the same process CPHFW took to analyze first steps towards reducing negative impacts, innovating the business model and accelerating industry change, we could see significant improvements in 3-5 years.
Last August, I had the pleasure of attending CPHFW and joining Creative Denmark for the launch of their white paper, Sustainability by Design. Having the opportunity to see, first hand, how Danish fashion brands plan to take even the smallest steps towards responsible manufacturing was extremely inspiring. The message is clear, we need stronger industry alignment as well as partnership between government and private sector interests. Beginning with a set of standards and guidelines, NYFW can go a long way to initiating large-scale change. Taking responsibility must first occur industry wide and globally in order to truly move towards sustainability.
“… We talk about responsibility rather than sustainability because there’s really nothing sustainable about fashion,” said Barbara Potts, Co-Founder of Saks Potts (WWD).

Sustainability Requirements
We have to begin, and that means mapping small and achievable steps. The development of CPHFW 2023 Sustainability Requirements is a great place to start. Effective as of January 2023, the requirements stipulate that brands must achieve a minimum of 18 standards within six interlinked focus areas covering the value chain: strategic direction, design, smart material choices, working conditions, consumer engagement and shows. What if NYFW were to adopt its own version of standards within the same six focus areas?
The Six Interlinked Focus Areas:
STRATEGIC DIRECTIONThis area requires strategic action on international standards for human rights, environment and climate. From diversity and equality at the management level to not destroying unsold merchandise. This includes circular systems, investing in new technologies, optimizing logistics and knowledge sharing as part of new strategic requirements.
DESIGNThis area focuses on the design process to increase the quality and value of products economically and materially, and educate the consumer of these values.
SMART MATERIAL CHOICESAmong developing innovative solutions, this area requires at least 50% of collections to be certified, organic, upcycled or recycled and have a preferred materials list in place.
WORKING CONDITIONSThis area challenges existing social inequalities and the negative impacts of employment in the fashion industry with a call for human interaction, a sense of community and the appreciation of human life.
CONSUMER ENGAGEMENTThis area encourages brands to rethink current business models and to inform customers of the fast consumption of fashion that is deeply rooted in societal, behavioral, psychological and economic values and urgently influences consumer engagement.
SHOWSRequires zero waste or actions to offset carbon footprint while participating in shows.

While the requirements establish challenging guidelines to achieve, they are flexible enough for brands to work towards without being eliminated from fashion week participation. Keeping the requirements top of mind empowers brands to move forward. If NYFW were to adopt the requirements it could affect the industry more quickly. If big brands took small actions to fundamentally change manufacturing alone, the industry could move forward on a global scale.
Go Big on Going Small
As mentioned in my article last year at this time, President Biden would have been the first U.S. president to appoint a “fashion czar” on private sector and policy partnership for the industry. It is important that the public and private sector work together to establish a set of standards, defining action points and moving forward with protocols to affect change across supply chains, production, and working conditions.

CPHFW has identified a foundational framework that is agile and applicable. If NYFW adopts and scales a new framework, innovative companies can be both profitable and sustainable. By going big on going small NYFW and CPHFW could make significant gains towards a more sustainable fashion industry.
The post Sustainable Fashion from Copenhagen to New York: Go Big on Going Small appeared first on Garrott Designs.
June 26, 2021
America By Design in Denmark
Three yeas ago I visited Denmark on a grant to research futures studies and how Danish culture informs urban design and city planning. It was amazing to visit Denmark again just a few weeks ago to revisit these ideas. We were filming an international segment for America By Design; a television series about inspiration, disruption, and changing the game through the power of design! The show launched on ABC, CBS and NBC June 12, and will air Saturday nights through the end of July. From August you can binge watch the whole series all over again on Amazon Prime.
 Culture of Creativity
Culture of CreativityMost everyone in America loves LEGO. However, few people know that the beloved brick comes from Billund, Denmark. Why does it matter? Well, in Denmark creativity and learning through play is a cultural virtue that starts at childhood and ultimately influences the very design of cities and transportations systems in urban places. Design matters and this show gets down to what, why and how! Watch the July 10th episode to hear the whole story. For a little of what’s in store, check out a LEGO Story

The series celebrates innovation, ingenuity, and design excellence, featuring game-changing ideas and stories behind the great innovations that affect the way we live our lives. Here are a few more places and faces from behind the scenes.

Your next car just might be a bike, says Jens Martin Skibsted, founder of Biomega and designer at Manyone. I’m convinced after visiting Biomega and seeing the OKO e-bike for myself. The bike is now available in the U.S. at the Museum of Modern Art (MoMA) store. It really is as much a beautiful work of art as it is a seamless, quiet and sweatless ride. For a commuter in New York City, style, comfort and staying cool is a must have.

You won’t want to miss learning about Konditaget Lüders, a recreational space on top of a multi-story car park in Copenhagen’s Nordhavn district. The building also serves as a recycling center and battery, storing energy generated from solar panels on the rooftops of surrounding buildings. The show features an interview with Camilla van Deurs, City Architect of Copenhagen, and formerly a Partner and Director at Gehl.

It was an intense four days filming in all weather conditions. Laughter and collaboration kept the energy going through wind and rain. Find out which innovation will be the ultimate winner of the season. And, check out all the ways you can get involved here.


The post America By Design in Denmark appeared first on Garrott Designs.
February 14, 2021
Politics of Fashion: Biden & Copenhagen Fashion Week
Could fashion become a political prodigy for green policy? It might, if President Biden does indeed appoint a “Fashion Czar,” according to this article in Fast Company. “The fashion industry is responsible for 10% of the world’s carbon emissions and needs to be regulated like other big sectors.” With an industrial reach that spans the globe, it’s very difficult for any one country to take responsibility or impose policy to regulate and reduce the damage caused to the environment.
According to the article, “no single country has been forced to take ownership of the terrible damage it has caused to the planet and workers.” Given that it is a global problem, perhaps what’s needed is a united nations approach to collaboration from countries voluntarily taking responsibility to make the necessary changes.
 Copenhagen Fashion Week
Copenhagen Fashion WeekDenmark is taking responsibility and seeking to make impactful changes. Last week, Women’s Wear Daily reported an optimistic, purpose driven and sustainably committed fashion week from Copenhagen Fashion Week (CPHFW). As an industry veteran and “recovering” American fashion designer, I see renewed inspiration and hope for fashion on the horizon.
 With Liberty & Fashion For All
With Liberty & Fashion For AllIn the states, over the last eight years or so, we’ve been talking about democratizing fashion and debating the notion of sustainability as if it’s an off-brand marketing move towards a faddish trend that will never be monetizable.
CPHFW continues to put sustainability and accessibility out in front while providing a lifestyle in which we can all aspire and find purpose. The aggressive commitment to sustainability illustrates an action plan and measurable goals that could serve as inspiration to waffling US fashion houses.
 Global Fashion Agenda
Global Fashion AgendaEmerging from a difficult year for all and nearly a decade of struggle for fashion in general, it’s inspiring to have access to a destination fashion week that not only provides stylistic aspirations but an outline for a sustainable lifestyle. By providing a digital platform for fashion creators themselves, CPHFW opened up the important conversations and radical change the industry MUST take to survive. Ironically, in the United States, fashion is known more for the radical change it delivers rather than the adherence to the old methods in which it staunchly operates.
Women’s Wear Daily (WWD) shared perspective from Baum co-founders Helle Hestehave and Rikke Baumgarten which, to this former designer, could not be more on-point, “The standards outlined from Copenhagen Fashion Week are very important for all of the Scandinavian fashion brands — and we honestly hope they can even push for a global agenda. Our entire industry needs to adapt urgently and change the course of how we are running business.”
 The Fabric of Our Lives
The Fabric of Our LivesOne of the industry’s biggest demands for change is that of textiles, both at the manufacturing level as well as post-consumer waste. Silas Adler, creative director of Soulland tells WWD, “If we reach for new fabrics every season, it would be impossible to reach our goals. You need to change some of your fundamental ways of working and a textile family is the most extreme, from a design point of view. But you just need to step up your game and make sure you keep making the textile relevant season after season.”
Circular SystemsFashion has always been about creativity in the product, it’s time manufacturers also become creative about the whole cycle of fashion. While circular systems solutions are urgently needed in the fashion industry, the problem concerns many industries, global, urban and rural. Denmark continues to lead the charge with open dialog to solve circular problems collaboratively, through Circular City Week New York, March 22nd-28th. CCWNY is also accessible and open to the public, learn more and sign up here.
 United Nations for Design
United Nations for DesignThis past year has shown us how necessary and urgently we must innovate to stay ahead of the curve in many ways. As WWD observed, “It’s clear that Scandi designers are becoming as well versed in talking about certified textiles, carbon emissions and waste reduction, as they are about design or their seasonal inspirations.”
I hope that American brands will also commit to the movement and join the conversation sooner rather than later.
Like this Article? Check out what I had to say about Slow Fashion, and Olso Fashion Week 2019. Stay Inspired, subscribe to my Newsletter.
The post Politics of Fashion: Biden & Copenhagen Fashion Week appeared first on Garrott Designs.
Politics Fashion: Biden & Copenhagen Fashion Week
Could fashion become a political prodigy for green policy? It might, if President Biden does indeed appoint a “Fashion Czar,” according to this article in Fast Company. “The fashion industry is responsible for 10% of the world’s carbon emissions and needs to be regulated like other big sectors.” With an industrial reach that spans the globe, it’s very difficult for any one country to take responsibility or impose policy to regulate and reduce the damage caused to the environment.
According to the article, “no single country has been forced to take ownership of the terrible damage it has caused to the planet and workers.” Given that it is a global problem, perhaps what’s needed is a united nations approach to collaboration from countries voluntarily taking responsibility to make the necessary changes.
 Copenhagen Fashion Week
Copenhagen Fashion WeekDenmark is taking responsibility and seeking to make impactful changes. Last week, Women’s Wear Daily reported an optimistic, purpose driven and sustainably committed fashion week from Copenhagen Fashion Week (CPHFW). As an industry veteran and “recovering” American fashion designer, I see renewed inspiration and hope for fashion on the horizon.
 With Liberty & Fashion For All
With Liberty & Fashion For AllIn the states, over the last eight years or so, we’ve been talking about democratizing fashion and kicking around the notion of sustainability as if it’s an off-brand marketing move towards a faddish trend that will never be monetizable.
CPHFW continues to put sustainability and accessibility out in front while providing a lifestyle in which we can all aspire and find purpose. The aggressive commitment to sustainability illustrates an action plan and measurable goals that could serve as inspiration to waffling US fashion houses.
 Global Fashion Agenda
Global Fashion AgendaEmerging from a difficult year for all and nearly a decade of struggle for fashion in general, it’s inspiring to have access to a destination fashion week that not only provides stylistic aspirations but an outline for a sustainable lifestyle. By providing a digital platform for fashion creators themselves, CPHFW opened up the important conversations and radical change the industry MUST take to survive. Ironically, in the United States, fashion is known more for the radical change it delivers rather than the adherence to the old methods in which it staunchly operates.
Women’s Wear Daily (WWD) shared perspective from Baum co-founders Helle Hestehave and Rikke Baumgarten which, to this former designer, could not be more on-point, “The standards outlined from Copenhagen Fashion Week are very important for all of the Scandinavian fashion brands — and we honestly hope they can even push for a global agenda. Our entire industry needs to adapt urgently and change the course of how we are running business.”
 The Fabric of Our Lives
The Fabric of Our LivesOne of the industry’s biggest demands for change is that of textiles, both at the manufacturing level as well as post-consumer waste. Silas Adler, creative director of Soulland tells WWD, “If we reach for new fabrics every season, it would be impossible to reach our goals. You need to change some of your fundamental ways of working and a textile family is the most extreme, from a design point of view. But you just need to step up your game and make sure you keep making the textile relevant season after season.”
Circular SystemsFashion has always been about creativity in the product, it’s time manufacturers also become creative about the whole cycle of fashion. While circular systems solutions are urgently needed in the fashion industry, the problem concerns many industries, global, urban and rural. Denmark continues to lead the charge with open dialog to solve circular problems collaboratively, through Circular City Week New York, March 22nd-28th. CCWNY is also accessible and open to the public, learn more and sign up here.
 United Nations for Design
United Nations for DesignThis past year has shown us how necessary and urgently we must innovate to stay ahead of the curve in many ways. As WWD observed, “It’s clear that Scandi designers are becoming as well versed in talking about certified textiles, carbon emissions and waste reduction, as they are about design or their seasonal inspirations.”
I hope that American brands will also commit to the movement and join the conversation sooner rather than later.
Like this Article? Check out what I had to say about Slow Fashion, and Olso Fashion Week 2019. Stay Inspired, subscribe to my Newsletter.
The post Politics Fashion: Biden & Copenhagen Fashion Week appeared first on Garrott Designs.
September 2, 2020
Are We in a War with Wealth?
It takes a lot to move a big ship. Likewise, it takes a lot of investment to fund innovation and democratize access. There is a rising sentiment that Amazon has gotten too powerful, that it should be illegal to be a billionaire, and that Jeff Bezos doesn’t pay taxes. Today, it is unfortunate that innovative leaders like Michael Bloomberg are being disregarded on the basis of their wealth when evidence shows that many entrepreneurs make a sizable contribution to people and community along their entrepreneur’s journey. This raises the question, are we at war with wealth?

Democratizing Access
Throughout history, innovation has led to efficient systems that democratize luxuries and create new opportunities for everyone. These innovations have improved the quality of life for all, opening new economic opportunities. The light bulb and city-wide electricity grids attest to the possibility of a luxury once available only to the wealthy becoming a commodity for all.
The Genius of Amazon
A modern example is illustrated in a recent issue of The Economist that describes just how essential Amazon has become to America and Europe during the pandemic crisis. The article, The Genius of Amazon sheds some light on the investment and risk involved with growing Amazon and being Jeff Bezos. The writer cites challenges Amazon overcame during the surge by stretching financial resources to maintain services the consumer has come to expect. According to the article, at the early stages of the U.S. shut down, Amazon hired 175,000 additional staff, equipped them with the proper PPE during a shortage, leased 12 new cargo aircrafts bringing the total fleet to 82 and stabilized an e-commerce surge on the infrastructure of cloud computing payment systems.
Who is Jeff Bezos?
Can Jeff Bezos as a money monger be the whole narrative that comes with a person in his position? For a guy who spent well over a decade packing boxes full of books in his basement at a loss, it seems like there are quicker ways to become greedy. That’s not to say that he’s an altruist, necessarily, it’s clear that the debate about Amazon employee wages and working conditions is an area that has demanded improvement while profitability remains a goal. However, he clearly is a man with a mission to create value in doing so. And he does.
Ecosystem of Invention
So far, there is no evidence that Bezos or Amazon has committed tax fraud but simply utilizes the tax system that exists to support business growth and entrepreneurship in the U.S. I’ve talked with leaders of other countries who admire our tax incentives for entrepreneurial businesses. They tell me there is little, if any, opportunity for a single person to start a business in those countries. For entrepreneurs that do manage to launch a business, the failure rate is very high. Speculations about how much tax Amazon or Bezos should pay, seem to have more to do with profit and loss from the various branches of Amazon separate from the entire ecosystem. As illustrated in The Economist’s Amazon Briefing, money is taken from the rich arm, currently Amazon Web Services (AWS), which enables Zoom calls and Netflix streaming among other things, to feed the challenged arms of Amazon’s business such as logistics, distribution, and supply chain. When things were “normal” those monies were distributed to Bezo’s side gigs including Haven Healthcare, a non-profit aimed at reducing cost of healthcare, Kuiper, a satellite-broadband venture and Blue Origin, his rocket company quietly competing with Elon Musk.
Innovation For All
As The Economist’s, Amazon Briefing illustrates, It does indeed take a lot to move big ships. While these companies and billionaires should certainly be held accountable and monitored for unethical practices, it is also essential that these visionaries are able to pursue innovations that contribute to the quality of life for all, in good times and bad.
Read The Economist, Genius of Amazon , Read The Economist, Amazon Briefing
The post Are We in a War with Wealth? appeared first on Garrott Designs.
April 14, 2020
Practical Utopia vs. Global Pessimism: An Interview with Valentino Gareri
As we move into spring, the month of April brings a reminder promising rebirth with Easter, survival of a plague with Passover and respect for the environment with Earth Day. To say the least, we are experiencing a deeply pivotal moment in time that is forcing us to reconsider how we work, our lifestyles and our impact on the environment.
I am deeply inspired to have had the opportunity to chat with Valentino Gareri, founder of Valentino Gareri Architectural Atelier & Senior Designer at BIG, during Build Expo NYC 2020. It was one of the last events I was able to attend before New York City shut down under Covid-19 quarantine mandates. The young and talented Valentino Gareri is Italian born and a new resident of New York City, his perspective is poignantly relevant and timely.
We talked about the future of urban design, what’s happening in Italy, biotechnology and and the architect’s role in designing a better future. I am excited to present to you 5 questions for Valentino Gareri.
 Credit: Valentino Gareri Architectural Atelier
Credit: Valentino Gareri Architectural AtelierGarrott Designs: At Build Expo, you spoke about how good architecture doesn’t have to be expensive, that it must solve a problem, contribute to the community it serves and respect the culture and environment in which it exists. Given the effect Covid-19 has had on your homeland of Italy, matched with your perspective as a new resident of New York City, how can architecture contribute to the public health and well-being of our future cities?
Valentino Gareri: I believe that Art has the duty to inspire people to hope for a better world, especially in a moment of global pessimism and warning like this.
Architecture is the discipline which, more than the other arts, has the power to shape our world and our future. The primary role of architects is to respond and give solutions to specific needs through the shape and geometry of their design. The projects I presented at the New York Build Expo, are very different from each other but have in common this generational purpose and are all answers to natural calamities or emergencies.
 Credit: Valentino Gareri Architectural Atelier Notre Dame, New Roof proposal, Paris, France
Credit: Valentino Gareri Architectural Atelier Notre Dame, New Roof proposal, Paris, France Credit: Valentino Gareri Architectural Atelier Notre Dame, New Roof proposal, Paris, France
Credit: Valentino Gareri Architectural Atelier Notre Dame, New Roof proposal, Paris, FranceThe current pandemic is going to deeply change the society and the entire world; and it is going to radically affect Architecture and the way cities will be designed in the future.
Scientific studies highlighted a direct relationship between the speed of diffusion of the Covid-19 and the level of pollution of the areas most affected by the pandemic. Apparently, the particles pollution became vectors that carried the virus spreading it faster and wider.
This should, again, remind us how sustainability is fundamental for the future of our planet. However, it is not enough to discuss sustainability anymore, we should rather start talking about the ability-to sustain and support the fragile relationship between ecosystems, humans and mother nature. Not only by designing energy-efficient buildings, but rather by adding improvements to the built world, both at environmental and social levels.
In order to improve the environmental sustainability we have built dense and high cities. This pandemic is showing that we might have to re-think the model of urban physical densification, and rather move towards a digital and technological intensification.
 Credit: Huawei
Credit: HuaweiMore software, less hardware. For example, in ‘smart cities’ like Shenzhen or Songdo, big data analysis largely anticipated where new viral transmission clusters could emerge and have strongly reduced the spread of the virus. Urban non-places (abandoned and not developed city areas) can become new social and vital hearts in this digital revolution.
For these reasons, Future cities will need small, gentle injections within the existing urban grain, rather than big surgery sessions.
Garrott Designs: You presented an exciting modular concept for a community in Africa . A brilliant solution for developing communities. How do you see modularity playing a role in a modern city like New York toward a sustainable future?
Valentino Gareri:: The diffusion on a large scale of modular design in the future can drastically reduce the costs of construction: repetitive and prefabricated components are fast, easy to produce and mount: it is the way they are assembled and combined together that brings, at the end, something extraordinary.
 Credit: Valentino Gareri Architectural Atelier
Credit: Valentino Gareri Architectural AtelierIn the case of the prototype of modular school for Africa, the module is the result of the combination between a local need (the rain water collection) and the vernacular architecture and local art. A common element of everyday life is turned into Architecture.
 Credit: Valentino Gareri Architectural Atelier
Credit: Valentino Gareri Architectural AtelierAt the Expo I talked about ‘UTOP-TICAL ARCHITECTURE’, an architecture where the utopia and the practical are merged together.
In a high and dense city like New York, the adoption of modular and light components can be used in the future either as addition to existing buildings, or as a way to reduce the buildings cost by adopting repetitive modules for new developments, in particular in the residential industry and social housing.
 Credit: Valentino Gareri Architectural Atelier
Credit: Valentino Gareri Architectural AtelierGarrott Designs: Biotechnology in the built environment is emerging into mainstream consciousness with exhibitions like Nari Oxman’s Material Ecology at the MoMA. What developments in biotechnologically fabricated materials are you most excited about? What would you build if you had access to that material right now?

Valentino Gareri: The emerging and fast development of biotechnology, together with the wider and accessible application of the 3D-printing technology, is something exciting and that can bring to a new era of architectural design.
Bio-technology highlights an interesting dichotomy between nature-inspired design and design-inspired nature. The word itself ‘BIO-TECHNOLOGY’ puts together worlds which are at opposite latitudes: BIOLOGY and TECHNOLOGY.
Likewise, Architecture fluctuates in the constant and delicate balance between art and science, poetry and physics, nature and urbanism. The equilibrium between these opposite faces is at the basis of the history of Architecture, since the time Man designed and built the first shelter.
Bio-technology could allow, one day, to design buildings where the façade behaves exactly as the skin of the human body, regenerating itself during its life and reducing the aging effects of time and weather. They can be made of natural and recyclable elements, replacing the polluting production of materials like plastic, steel and aluminum.
 Neri Oxman ecological building materials
Neri Oxman ecological building materialsAnd again, bio-technology can create buildings envelopes which can absorb environmental pollution and produce clean energy, as nature does through the photosynthesis process.
 Butterfly Sanctuary Concept Design by TerreformONE- an example of bio-envelope exterior
Butterfly Sanctuary Concept Design by TerreformONE- an example of bio-envelope exteriorGarrott Designs: What are the essential values that inspire your work? How are you bringing those elements to your projects?
Valentino Gareri: In a society where, for the first time, new generations are starting to doubt that their future will be better from their parent’s, Architecture, as all the other forms of art, should inspire people to dream. That’s why I like to think that ‘DREAMING IS MORE’. Society is changing, and much faster than the past.
 Credit: Valentino Gareri Architectural Atelier
Credit: Valentino Gareri Architectural Atelier Credit: Valentino Gareri Architectural Atelier
Credit: Valentino Gareri Architectural Atelier‘Dreaming is more’ is not a disrespectful reaction to the Masters of the past, but rather an awareness that Architecture can’t speak anymore to the new generations with a language of 3 generations ago. Moreover, ’dreaming is more’ doesn’t mean designing unfeasible and expensive buildings.
 Credit: Valentino Gareri Architectural Atelier
Credit: Valentino Gareri Architectural AtelierGood architecture is priceless, not price-full. Architects should be driven by the desire of creating out-of-ordinary buildings, but at the same time being cost and environmentally respectful. Architects have the responsibility to give a big contribution to make today and our planet a better place where we can live, and tomorrow the best home for new generations. This is the most important value that drives my work, that rather than a job, I see as a mission.
 Credit: Valentino Gareri Architectural Atelier
Credit: Valentino Gareri Architectural AtelierValentino Gareri
Founder of Valentino Gareri Architectural Atelier & Senior Designer at BIG
Website: https://valentinogareri.com/
The post Practical Utopia vs. Global Pessimism: An Interview with Valentino Gareri appeared first on Garrott Designs.
March 31, 2020
The Sloth: A Model for Urban Design
What does a three-toed sloth have in common with New York City? Well, obviously not speed and agility. Turns out, the three-toed sloth has its own ecosystem that fosters a diverse range of life in it’s fur high above the forest floor. You could say the sloth is similar to a high rise residential building or, almost literally, an eight floor commercial building concept in Nolita. I’m sure you’re thinking that’s a stretch. Allow me to explain.

The Moth and the Sloth
The three-toed sloth is a precarious creature and perhaps inspiration towards building future cities. This particular sloth has it’s very own ecosystem of bacteria and algae that not only is vital to its health but also supports a community of arthropods including moths and beetles. In fact, the entire life cycle of the Cryptoses Choloepi (sloth moth) exclusively relies on the three-toed sloth’s fur for nutrients, a safe breeding ground and eventually laying its eggs in the sloth’s dung on the forest floor to begin the life cycle all over again.
Design by Nature
Climate change, sustainability and public health have become a priority as urban areas are expected to double in population by 2050 according to the United Nations Department of Economic and Social Affairs.
In recent months, I’ve visited two fascinating ecology driven exhibitions at the Cooper Hewitt and the MoMA. These museums are bringing to public awareness future facing concepts that combine nature with design. As I write this, NYC museums are closed to the public due to Covid-19 shelter-in-place mandates. While we face a global pandemic, there is increasing opportunity for cross disciplinary designers, engineers and artists looking towards nature to build better cities and better solutions for public and environmental health. No doubt, things are scary, but they can also inspire positive change.
Butterflies in Nolita
So why am I comparing the sloth’s micro-ecozone to an eight story commercial building concept in Nolita? Well, because a relatively new start-up company called Terraform One (Open Network Ecology) noticed how loss of habitat and climate change has jeopardized the Monarch butterfly population which will have dire consequences to our ecosystem and agriculture. During the Nature — Cooper Hewitt Design Triennial exhibition, I got the chance to chat with Co-founder Mitchell Joachim and see the model for myself.

What makes Terraform ONE awesome is their mission to create smart urban innovations that elevate the quality of life in our cities, contribute positively to our ecosystem while reconnecting people with nature. Enter the Monarch Sanctuary, our metaphorical sloth scenario to urban design.

The Monarch Sanctuary will be a new commercial construction integrating a monarch habitat into the facade, roof and atrium. This “vertical meadow” or terrarium will serve as a climate-controlled, all season incubator providing a safe haven of nourishment for all stages of the butterfly’s life-cycle. Providing urban sanctuary to butterflies facilitates the migration patterns necessary to maintain the ecosystem and agriculture that rely on insect populations. Additionally, the terrarium, rooftop and atrium provides bio-active green space for the health and well-being of its human inhabitants. The building will offer a striking example for humans coexisting with diverse life forms in the city while reconnecting urban dwellers with nature. Not at all unlike the Sloth being an essential host to the entire life-cycle of the sloth moth.
Bacteria and the Built Environment
According to a 2014 study funded by the International Cooperative Biodiversity Group (ICBG-Panama), and the College of Agriculture and Life Science University of Arizona, bacteria from sloth fur could help humans too. The algae and bacteria found on the sloth could be a powerful force against bacterial infections associated with Malaria, among others, and effective against the breast cancer strain MCF-7. Like the sloth, certain forms of bacteria are vitally essential to our health and well-being. Recent studies have shown the absence of healthy gut bacteria in people are linked with depression, anxiety, common food and skin allergies, as well as asthma. Building bacteria back into the environment could be a more sustainable move.
 Photo credit SOM © Albert Vecerka Esto
Photo credit SOM © Albert Vecerka EstoIn 2015, architecture firm Skidmore, Owings and Merrill (SOM) designed and built the Bronx Public Safety Answering Center II (NYC’s 9-1-1 call center) with experimental “bio-walls.” For security reasons the building has few windows and thus, limited natural light or view to the outside.
 Photo Credit: SOM
Photo Credit: SOMFor health and wellness purposes the interior’s integrated “bio-walls” contain microbes in the plants’ roots that filter out volatile organic compounds (VOCs), formaldehyde and other toxins in addition to reducing energy consumption while producing oxygen. The bio-walls contribute to the health and well-being of the people inside the facility. Speaking of bacteria in the built environment…
Material Ecology
Neri Oxman is the director at Mediated Matter Group and a professor of media arts and sciences at the Massachusetts Institute of Technology’s Media Lab. An innovator at the intersection of biology and technology, Oxman coined the term “material ecology” to describe techniques, objects, materials and construction developed in collaboration with nature, technology and cultural context.

Walking through the “Material Ecology” MoMA exhibition, I was inspired by the idea of growing building materials with bacteria, fungi and melatonin. You can already buy furniture grown from mushrooms. More immediately viable were the Aguahoja I materials created as plastic substitutes printed from biopolymers including cellulose, pectin, calcium carbonate, acetic acid, and vegetable glycerin. The water based materials are designed to decay over time making them perfect prospects for packaging materials and single use consumer products.


Additionally, the Vespers death masks were infused with natural minerals and bacteria. One even encapsules what would be the deceased’s last breath. Biological design that captures our imagination, immortalizes human frailty and creates solutions to wicked problems such as waste and sustainable materials goes a long way towards inspiring a better future.

Oxman and her research team operate through a methodological approach called the Krebs Cycle of Creativity. It is a framework that considers art, science, engineering and design as synergistically informing one another. To paraphrase, information is science converted to knowledge, engineering converts that knowledge into utility, design gives utility cultural context and art takes everything into consideration and questions the perceptions of the world. We need greater forms of collaborations, like this, to solve the world’s most wicked problems.

A Call to Action
For the first time in history the entire globe is experiencing a crisis simultaneously. With the spread of Covid-19 coronavirus, the pandemic has also demonstrated the effect we’ve had on the environment. Satellite observation shows China’s air pollution reduced after weeks of shut down and fish return to clearer waters in Venice. Slow reaction and panic have demonstrated how unprepared we are and how little we understand the environment and our impact upon it. It’s time we take an objective, non-political look at what’s happening and call upon scientists, designers and engineers to co-create a better future. It is the role of creative visionaries in art, design, science, technology and business who pull our culture forward into possible futures.

The post The Sloth: A Model for Urban Design appeared first on Garrott Designs.
March 16, 2020
Changing the World One light Bulb at a Time
Sustainability and new energy codes were a big part of the conversation last week at New York City Build Expo 2020. The city of New York has updated local laws to cut greenhouse gas emissions 30 percent by 2030. While the new Energy Conservation Codes detail many needed upgrades, lighting design has a major opportunity for growth. For product developers, there is a huge and rapid market that needs to be served right now.

In fact, by January 1, 2025 all commercial buildings as well as common areas in residential properties larger than 25,000 sq. ft. must be upgraded to meet the new mandates. This means, new products and smart lighting systems will need to supply the market quickly.

As much as compliance and logistics can weigh down inspiration, I’d like to share some insights on lighting design trends that will benefit developers, designers and property owners towards the future of greener commercial and residential spaces.
‘Hospidential’ is a Thing
People desire seamlessly luxurious experiences every day. The future of lighting design is emerging from hospitality influencing residential and retail. At the same time, residential is influencing the workplace environment.

Smart home technology and innovation are driving diffused and ambient forms of lighting. LED and connected devices are energy efficient and allow versatility. Low energy consumption forms of lighting are creating the illusion of more space and mimicking phases of the day. A well-lit space offers a backdrop that facilitates multi-functional spaces, community and neurodiversity in a sensory pleasing environment.
Motivate Change with these Action Points

Overall the smart home market is expected to grow from $76.6 billion in 2018 to $151.4 billion by 2024.Lighting is getting technical, offering mood and versatility with automated features. Designers are choosing lighting that facilitates versatility of a space, enhances surfaces, wall color and even skin tones in the environment.
Be Subtle: diffused and hidden sources of lighting create softer , cozier spaces. Look for products that install easily into the background of a space.
Offer Versatility: ensure lighting offers a range of tone and intensity allowing a space to have multiple uses such as work, entertaining, and relaxing.
Give Control: offer systems with multiple control functions such as voice, remote app access and automated hub settings allowing people to easily adjust wherever they are in proximity to location.
Inspire Ideas: Share the story of what technical aspects of this system or product can do for a space. Explain various uses for the product and how it optimizes the space in which it’s intended.
Conserve Energy: energy efficiency and long life products are a key value. Make it easy to replace parts when necessary.
Top 3 Trends Driving Lighting Design
I’ve tracked three trends that inspire the future of lighting in compliance with energy efficient efforts across interior design tradeshows since 2018. Developers, designers and property owners can leverage these design insights as they upgrade to compliance by 2025.
Recessed and LED
MoMA for the Home
Back Stage Lighting
Recessed and LED

Recessed and LED strips illuminate statement furniture, highlight architectural embellishments or create the feeling of another room in smaller spaces.
Offer LED lighting strips that are adjustable in length for versatility. Create accessories and systems that are accessible and upgrade with technology.
Offer a fully connective lighting system that can be controlled from a central source independently. Think voice activation, app controls and a central hub system.
Think creatively about other decorative combinations of lighting such as wallpaper, statement furniture, wall hangings and accessories.
MoMA for the Home

Modern sculpture inspired chandeliers and lamps give the feeling of boutique hotel sophistication with the presence of statement art to a space.
Designs that elevate a space to hospitality, retail or museum store appeal draw interest by offering personalization through self-expression.
Re-purposed and industrial materials offer a contemporary look as well as an environmental awareness value in aesthetics.
Indirect lighting, glowing and diffused reflections are key design elements to a sculptural piece. Form follows function in the case of these statement objects.
Back Stage Light

Backstage boudoir trends illuminate mirrors and closets giving the dressing room and bathroom a sense of glamorous preparation for the world stage.
Lighting used for social media and on-line retail photography inspire bathroom and closets or dressing rooms. Mirrors that illuminate the face and body from flattering angles create an instant beauty influencer photo opp.
Lighting that changes tone, hue and intensity can turn a bathroom into a spa or a closet into a runway.
Be the Change the You Want to See in the World

For more information on regulation compliance and product ideas, check out Regency Lighting’s Blog. For commercial consultation and specification, check out SLS Lighting. You can change the world, one light bulb at a time.
The post Changing the World One light Bulb at a Time appeared first on Garrott Designs.



